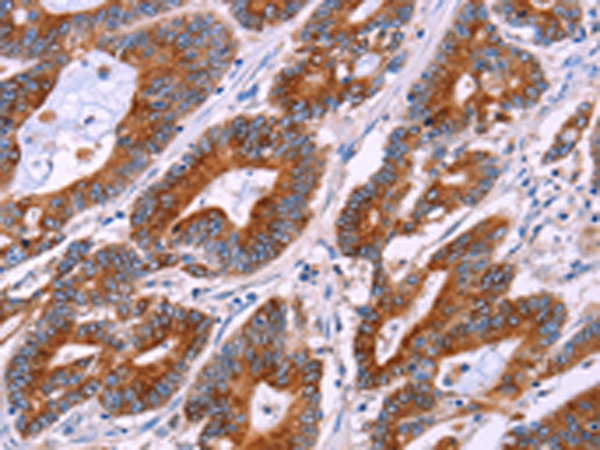

-
分类: 科研抗体货号: P11248别名: TKT; MIG20a; NTRKR3; TYRO10应用: IHC反应种属: Human, Mouse
-
分类: 科研抗体货号: P11225别名: BOKL; BCL2L9应用: IHC反应种属: Human, Mouse, Rat
-
分类: 科研抗体货号: P11267别名: MG1; MUC5; MUC9; MUC-5B应用: WB,IHC反应种属: Human
-
分类: 科研抗体货号: P11244别名: BAR; RNF47应用: IHC反应种属: Human
-
分类: 科研抗体货号: P11266别名: MLP, SMUC, MUC-2应用: IHC反应种属: Human
-
分类: 科研抗体货号: P11261别名: HGFR; AUTS9; RCCP2; c-Met应用: IHC反应种属: Human, Mouse, Rat
-
分类: 科研抗体货号: P11265别名: MUC-6应用: IHC反应种属: Human
-
分类: 科研抗体货号: P11242别名: ARB1; ARR1应用: WB,IHC反应种属: Human, Mouse, Rat
-
分类: 科研抗体货号: P11257别名: GP110; LAMP4; SCARD1应用: IHC反应种属: Human
-
分类: 科研抗体货号: P11241别名: ALL; CML; PHL; BCR1; D22S11; D22S662应用: IHC反应种属: Human, Mouse

鄂公网安备42018502007531号
鄂公网安备42018502007531号

